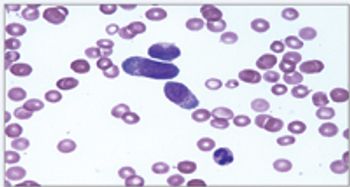
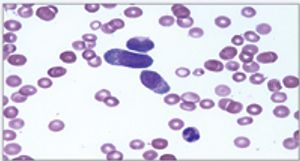

Evaluation of a properly prepared blood smear by the trained human eye is an absolutely necessary compliment to machine evaluation of peripheral blood in all species.

Evaluation of a properly prepared blood smear by the trained human eye is an absolutely necessary compliment to machine evaluation of peripheral blood in all species.

One of the most commonly used diagnostic modalities in veterinary medicine is cytology.

In the diagnostic work up of any case, one of the most frequently used tests is the complete blood count (CBC).

An effusion is defined as the escape of fluid into a part. Effusive processes can occur in essentially any tissue in the body.

Cytology is an extremely useful tool that can be employed in any practice.

An acute abdomen is defined as the acute onset of abdominal pain. Possible underlying etiologies are broad ranging, and include the gamut from trauma to infectious and neoplastic causes.
Published: October 1st 2008 | Updated:

Published: October 1st 2008 | Updated:

Published: October 1st 2008 | Updated:

Published: October 1st 2008 | Updated:

Published: October 1st 2008 | Updated:

Published: August 1st 2007 | Updated: